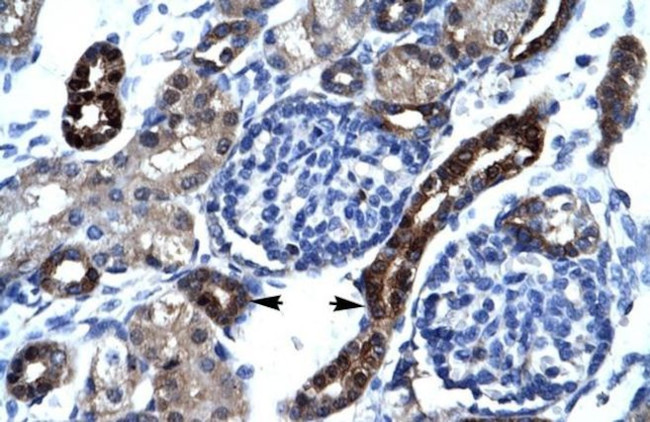
AKAP17A Antibody in Immunohistochemistry (IHC)

Search
Invitrogen
AKAP17A Polyclonal Antibody
{{$productOrderCtrl.translations['antibody.pdp.commerceCard.promotion.promotions']}}
{{$productOrderCtrl.translations['antibody.pdp.commerceCard.promotion.viewpromo']}}
{{$productOrderCtrl.translations['antibody.pdp.commerceCard.promotion.promocode']}}: {{promo.promoCode}} {{promo.promoTitle}} {{promo.promoDescription}}. {{$productOrderCtrl.translations['antibody.pdp.commerceCard.promotion.learnmore']}}
产品信息
PA5-40844
宿主/亚型
分类
类型
抗原
偶联物
形式
浓度
规格
保存条件
运输条件
RRID
产品详细信息
Peptide sequence: NWEVMERLKG MVQNHQFSTL RISKSTMDFI RFEGEVENKS LVKSFLACLD
Sequence homology: Dog: 100%; Horse: 100%; Human: 100%; Rat: 93%
靶标信息
DXYS155E is a gene found in the pseudoautosomal region of the distal short arms of the X and Y chromosomes, and appears to be ubiquitously expressed.
仅用于科研。不用于诊断过程。未经明确授权不得转售。